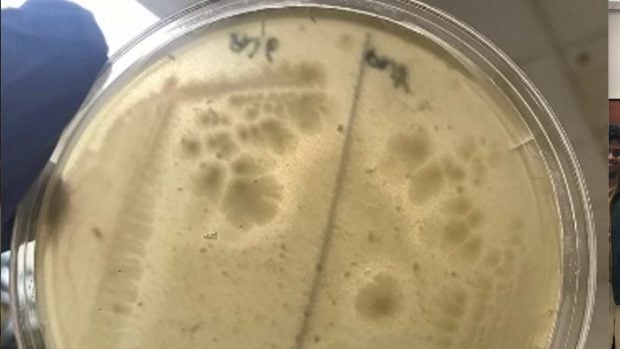

La saliva, clave contra la alergia al cacahuete, según el hospital La Princesa y la Universidad de Canadá
El estudio se ha publicado en la prestigiosa revista científica americana Cell Host & Microbe

Fact checked
Este artículo de OkSalud ha sido verificado para garantizar la mayor precisión y veracidad posible: se incluyen, en su mayoría, estudios médicos, enlaces a medios acreditados en la temática y se menciona a instituciones académicas de investigación. Todo el contenido de OkSalud está revisado pero, si consideras que es dudoso, inexacto u obsoleto, puedes contactarnos para poder realizar las posibles modificaciones pertinentes.
Un nuevo estudio publicado recientemente en la revista Cell Host & Microbe por investigadores del Instituto de Investigación Sanitaria del Hospital de La Princesa (IIS Princesa) en Madrid y de la Universidad McMaster en Canadá ha revelado una sorprendente conexión entre las bacterias que habitan en la boca y la forma en la que nuestro sistema inmune reacciona frente a alérgenos alimentarios, como puede ser el cacahuete.
Los investigadores han descubierto que bacterias del género Rothia, que viven de forma natural en la boca, tienen la capacidad de degradar las proteínas del cacahuete que provocan reacciones alérgicas, pudiendo prevenir la manifestación más severa de la enfermedad: la anafilaxia, una reacción aguda, potencialmente mortal, que puede desarrollarse en pocos minutos.
Los investigadores observaron cómo proteínas altamente alergénicas del cacahuete eran digeridas por este género bacteriano. Además, cuando estos digeridos se utilizaban como estímulo sobre células alérgicas, las respuestas eran inferiores a las generadas con cacahuete completo sin digerir por bacterias orales. Por otro lado, en modelos de ratón colonizados con bacterias del género Rothia, se reducía la gravedad de la reacción alérgica tras la administración oral de cacahuete. También se observaron respuestas menos severas cuando ratones alérgicos recibían cacahuete previamente digerido por este género bacteriano.
Ensayos con alérgicos al cacahuete
Finalmente, los científicos demostraron que, en dos cohortes de pacientes alérgicos al cacahuete del Hospital Mass General de Boston y del Hospital Monte Sinaí de Nueva York, aquellos con mayor abundancia en saliva de bacterias con capacidad de degradar el cacahuete, como Rothia, mostraban una mayor tolerancia a la exposición al alérgeno. Es decir, presentaban un umbral más alto antes de experimentar una reacción alérgica.
Este hallazgo puede explicar, en parte, las diferencias entre pacientes en cuanto al riesgo de desarrollar reacciones alérgicas frente a alimentos y podría ayudar a predecir quiénes son más susceptibles. Además, abre la puerta a nuevas estrategias terapéuticas para tratar las alergias alimentarias, especialmente al cacahuete, ya que se estima que entre el 1% y el 2% de la población mundial podría ser alérgica a este alimento, uno de los más asociados a la anafilaxia.

Microbiota, posible alternativa terapéutica
El estudio abre la puerta al desarrollo de tratamientos que aumenten la presencia de estas bacterias beneficiosas, lo que podría contribuir a reducir las reacciones alérgicas. En este sentido, la intervención sobre la microbiota —por ejemplo, mediante probióticos específicos— supone una nueva vía para abordar un problema de salud pública en aumento como son las alergias alimentarias.
En lugar de centrarse únicamente en el desarrollo de fármacos, la modulación de la microbiota, incrementando la abundancia de ciertas bacterias, podría ofrecer una alternativa terapéutica innovadora y eficaz para reducir riesgos y mejorar la tolerancia a alimentos potencialmente peligrosos.
La investigación ha sido liderada por los doctores Rodrigo Jiménez, jefe del Grupo de Investigación en Inmunidad Tipo 2 del IIS Princesa, y Alberto Caminero, profesor del Departamento de Medicina de la Universidad McMaster, en colaboración con sus respectivos equipos científicos.